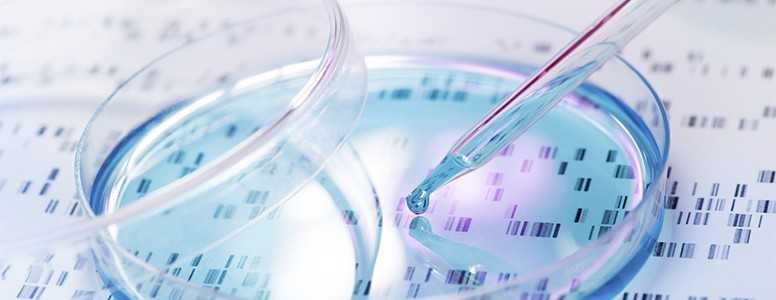

Pig islet cell transplantation could soon be used to help treat type 1 diabetes in Japa, it has been announced.
The country has just eased its rules on transplants of animal cells and organs to humans. The rules had previously forbid the practice over fears pig viruses could pass on infection.
Researchers from the National Center for Global Health and Medicine plan to conduct the first transplant on people with type 1 diabetes in 2019.
Pigs islet cells are considered as being suitable for use in humans because of the structural similarity between human insulin and porcine insulin (insulin from pigs).
Islet transplantation
If the pig islet cell transplants are successful, it may mean that more people with the condition are eligible for islet cell transplants. Currently, there is a lack of human islet cell donors across the world.
Islet cell transplants have a number of key benefits. They can allow people with type 1 diabetes to come off insulin injections, or at least to significantly reduce the amount of insulin that needs to be taken.
The transplants also give control of sugar levels back to the body which often means a greatly reduced risk of severe hypoglycemia occurring.
The downside of islet cell transplantation is that immunosuppressant drugs need to be taken for life to prevent the autoimmune attack of type 1 diabetes destroying the transplanted cells. The immunosuppressant drugs have side effects and can leave the body more exposed to infection.
The announcement comes five years after researchers found human organs could be grown inside pigs for use in transplant operations.
Diabetes.co.uk has previously reported on successful clinical trials, involving porcine islet cell transplants, that have been carried out in Russia.
What's new on the forum? ⭐️
Get our free newsletters
Stay up to date with the latest news, research and breakthroughs.